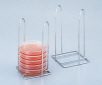
AS ONE Petri Dish Stand, 페트리디쉬 스탠드

AS ONE Petri Dish Stand, 페트리디쉬 스탠드
상품 한눈에 보기
스테인리스(SUS304) 재질로 내구성이 뛰어난 페트리디쉬 스탠드. 시료가 담긴 상태로 인큐베이터에 직접 넣을 수 있으며, 오토클레이브 멸균이 가능합니다. φ75mm 및 φ90mm 페트리디쉬 수납 가능.
브랜드: AS ONE
✨AI 추천 연관 상품
AI가 분석한 이 상품과 연관된 추천 상품들을 확인해보세요
연관 상품을 찾고 있습니다...
특징
- 시료가 들어 있는 페트리디쉬를 그대로 인큐베이터에 넣을 수 있습니다.
- 오토클레이브가 가능합니다.
사양
| 항목 | 내용 |
|---|---|
| 재질 | 스테인리스(SUS304) |
| 수납 가능 페트리디쉬 | φ75mm용 / φ90mm용 |
🏷️AS ONE 상품 둘러보기
동일 브랜드의 다른 상품들을 확인해보세요

AS ONE
AS ONE Diaphragm Accurately Trace Chemical Feed Pump Smooth Flow Pump Q Series, 다이어프램 정밀미량 약주펌프
4,239,000원

AS ONE
AS ONE Static Electricity Removal Tape, 정전기 제거 테이프
33,000원

AS ONE
AS ONE Petri Dish Stand, 페트리디쉬 스탠드
38,000원

AS ONE
AS ONE Pipet Adaptor, 피펫용 어댑터
84,000원

AS ONE
AS ONE IntergRated Sight Glass, 일체형 관찰창
배송/결제/교환/반품 안내
배송 정보
| 기본 배송비 |
| 교환/반품 배송비 |
|
|---|---|---|---|
| 착불 배송비 |
| ||
| 교환/반품 배송비 |
| ||
결제 및 환불 안내
| 결제수단 |
|
|---|---|
| 취소 |
|
| 반품 |
|
| 환급 |
|
교환 및 반품 접수
| 교환 및 반품 접수 기한 |
|
|---|---|
| 교환 및 반품 접수가 가능한 경우 |
|
| 교환 및 반품 접수가 불가능한 경우 |
|
교환 및 반품 신청
| 교환 절차 |
|
|---|---|
| 반품 절차 |
|
문의 0
로그인 후 문의를 할 수 있습니다.